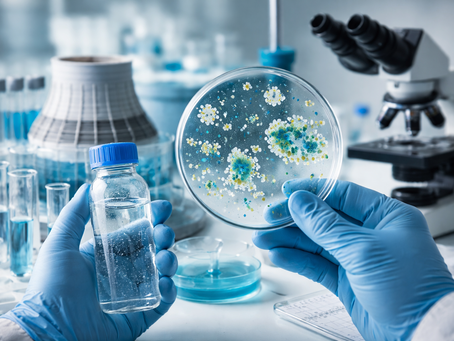
Gestão de Risco de Legionella: Como Aplicar Uma Abordagem Baseada Em Risco

top of page


Norovírus e surtos em comunidades sem tratamento de água
Entre os agentes infecciosos responsáveis por surtos de gastroenterite aguda em todo o mundo, poucos apresentam a capacidade de disseminação e impacto epidemiológico observados no norovírus.
Keller Dantara
2 de mar.9 min de leitura


Avaliação de Poluentes Industriais: fundamentos científicos, metodologias analíticas e implicações para a gestão ambiental
A industrialização desempenhou papel central no desenvolvimento econômico global ao longo dos últimos dois séculos. Setores como metalurgia, petroquímica, mineração, produção de energia, indústria farmacêutica, alimentícia e manufatura química contribuíram de maneira decisiva para a expansão tecnológica e para a melhoria de diversos indicadores socioeconômicos. Entretanto, esse progresso também trouxe desafios significativos relacionados à geração de resíduos e à emissão de p
Keller Dantara
2 de mar.9 min de leitura


Temperatura e Legionella: Faixas que Favorecem o Crescimento e Estratégias de Controle em Sistemas de Água
A qualidade microbiológica da água em sistemas artificiais — como redes prediais, torres de resfriamento, spas, hospitais e instalações industriais — representa um tema central para a saúde pública e para a gestão de riscos sanitários. Entre os microrganismos de maior relevância nesse contexto destaca-se o gênero Legionella, bactéria ambiental amplamente distribuída em ambientes aquáticos naturais e artificiais.
Keller Dantara
1 de mar.9 min de leitura


Análise de proteínas em efluentes e água: impacto ambiental e exigências legais
A crescente complexidade das atividades industriais, associada à intensificação da urbanização e da produção de resíduos, tem imposto novos desafios à gestão ambiental, especialmente no que se refere à qualidade da água e ao tratamento de efluentes.
Keller Dantara
1 de mar.8 min de leitura


Endotoxinas em água purificada: riscos ocultos na indústria
A qualidade da água purificada é um dos pilares fundamentais para a segurança de processos industriais em setores altamente regulados, como o farmacêutico, cosmético, hospitalar e de dispositivos médicos. Tradicionalmente, os parâmetros de controle da água incluem aspectos físico-químicos e microbiológicos clássicos — como condutividade, carbono orgânico total (TOC) e contagem bacteriana.
Keller Dantara
1 de mar.7 min de leitura


Responsabilidade Legal e Reputacional: Por Que Prevenir Legionella Evita Prejuízo
Em ambientes corporativos, hospitalares e industriais, a gestão da qualidade da água deixou de ser apenas uma questão operacional para tornar-se também um tema estratégico de responsabilidade institucional. Entre os diversos riscos microbiológicos associados a sistemas de água, a presença de bactérias do gênero Legionella ocupa posição de destaque devido ao potencial de provocar surtos de doença respiratória grave, conhecida como legionelose.
Keller Dantara
27 de fev.10 min de leitura


Portaria 888: o que é e quais análises de água são obrigatórias?
A qualidade da água destinada ao consumo humano é um dos pilares mais críticos da saúde pública e da segurança sanitária em qualquer sociedade. Em contextos urbanos e industriais cada vez mais complexos, garantir que a água distribuída esteja dentro de padrões adequados não é apenas uma exigência regulatória, mas uma necessidade estratégica para prevenção de doenças, manutenção da confiança institucional e conformidade legal.
Keller Dantara
27 de fev.7 min de leitura

Gestão de Risco de Legionella: Como Aplicar Uma Abordagem Baseada Em Risco
A presença de microrganismos em sistemas de água é uma realidade inevitável em ambientes naturais e construídos. Entre esses organismos, bactérias do gênero Legionella ocupam uma posição de destaque no debate científico e regulatório devido ao seu potencial de causar surtos de doenças respiratórias graves.
Keller Dantara
26 de fev.9 min de leitura


Enterovírus transmitidos pela água contaminada: implicações sanitárias, ambientais e tecnológicas
A água é um recurso essencial para a manutenção da vida e para o funcionamento de praticamente todas as atividades humanas. Entretanto, quando sua qualidade microbiológica é comprometida, ela se transforma em um vetor relevante de transmissão de agentes infecciosos.
Keller Dantara
26 de fev.10 min de leitura


Adenovírus e gastroenterite viral associada ao consumo de água imprópria
A segurança da água destinada ao consumo humano constitui um dos pilares fundamentais da saúde pública contemporânea. Embora avanços significativos tenham sido alcançados em sistemas de tratamento, monitoramento e distribuição de água potável ao longo das últimas décadas, episódios de contaminação hídrica ainda representam um desafio global relevante.
Keller Dantara
26 de fev.10 min de leitura


Monitoramento de Silicatos na Água: Frequência Ideal e Importância para Empresas
A qualidade da água é um fator crítico em múltiplos setores produtivos, especialmente naqueles que dependem de processos físico-químicos sensíveis, como a indústria farmacêutica, alimentícia, cosmética, energética e de tratamento de água.
Keller Dantara
25 de fev.8 min de leitura


Poliomielite e a ausência de saneamento básico: um desafio persistente para a saúde pública global
A poliomielite, frequentemente chamada apenas de pólio, é uma doença viral infecciosa que marcou profundamente a história da saúde pública mundial. Durante grande parte do século XX, surtos da doença provocaram paralisias permanentes em milhares de crianças e adultos, gerando forte mobilização científica e política para seu controle.
Keller Dantara
24 de fev.9 min de leitura


Qualidade da água de piscina: como evitar contaminação e riscos à saúde
A água de piscina, frequentemente associada ao lazer, ao esporte e ao bem-estar, também representa um ambiente complexo do ponto de vista sanitário e químico.
Keller Dantara
24 de fev.8 min de leitura
Análise microbiológica da água: exigências da Portaria GM/MS nº 888/2021
A água destinada ao consumo humano ocupa uma posição central na interface entre saúde pública, meio ambiente e desenvolvimento econômico. Embora frequentemente percebida como um recurso naturalmente disponível, sua qualidade depende de processos rigorosos de captação, tratamento, distribuição e monitoramento.
Keller Dantara
24 de fev.8 min de leitura


Quais são os limites de potabilidade da água segundo a Portaria 888? Um guia técnico e aplicado
A água destinada ao consumo humano ocupa um papel central na saúde pública, na sustentabilidade ambiental e na operação segura de atividades industriais, hospitalares e laboratoriais. Embora seja frequentemente tratada como um recurso básico e universal, sua qualidade depende de um conjunto rigoroso de parâmetros físico-químicos, microbiológicos e radiológicos, definidos por normas técnicas que buscam garantir a proteção da saúde da população.
Keller Dantara
24 de fev.7 min de leitura


Como detectar pentaclorofenol em água e solo: métodos laboratoriais e tecnologias
A presença de contaminantes orgânicos persistentes no meio ambiente é uma preocupação crescente para instituições científicas, órgãos reguladores e setores industriais. Entre esses compostos, o pentaclorofenol (PCP) ocupa uma posição de destaque devido à sua alta toxicidade, persistência ambiental e histórico de uso intensivo como biocida e preservante de madeira.
Keller Dantara
23 de fev.7 min de leitura


Surtos virais em escolas por água contaminada: desafios sanitários, vigilância epidemiológica e estratégias de prevenção
Instituições educacionais representam ambientes particularmente sensíveis à disseminação de doenças infecciosas. A concentração diária de crianças, adolescentes e profissionais em espaços compartilhados cria condições ideais para a circulação de patógenos, especialmente aqueles transmitidos por via fecal-oral.
Keller Dantara
23 de fev.9 min de leitura


Frequência de análise de água: o que a Portaria 888 exige das empresas
A água destinada ao consumo humano ocupa uma posição singular entre os insumos críticos de qualquer sociedade. Diferentemente de outros recursos, sua qualidade impacta diretamente a saúde pública, a produtividade econômica e a credibilidade institucional de empresas e órgãos públicos.
Keller Dantara
22 de fev.8 min de leitura


Água na produção de cerveja: importância da análise para qualidade final
A produção de cerveja, embora amplamente associada à arte e à tradição, é, em sua essência, um processo altamente técnico e sensível a variáveis físico-químicas e microbiológicas.
Keller Dantara
22 de fev.7 min de leitura


Criptosporidiose resistente ao cloro: risco em água mal filtrada
A segurança microbiológica da água destinada ao consumo humano é um dos pilares fundamentais da saúde pública. Desde o início do século XX, a cloração tem sido amplamente adotada como estratégia eficaz para a desinfecção da água, contribuindo decisivamente para a redução de doenças transmitidas por via hídrica, como cólera, febre tifoide e disenteria.
Keller Dantara
22 de fev.8 min de leitura
bottom of page
_edited.png)